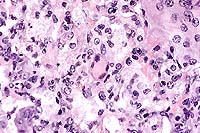

AFIP Diagnosis: Colon: Colitis, erosive, suppurative, subacute, diffuse, severe, with lymphoid depletion, abundant intraluminal suppurative exudate and numerous bacilli, Rhesus monkey (Macaca mulatta), primate.
Signalment: Male, juvenile, Rhesus monkey (Macaca mulatta)
History: This monkey arrived as one of a group of twenty monkeys. In quarantine, this monkey and two others began to have bloody diarrhea with frank blood. He was treated symptomatically. His appetite decreased. Symptomatic therapy continued, but the monkey's condition deteriorated and he became hypothermic and non-responsive. At this point he was euthanatized, and a necropsy was performed.
Gross Pathology: Petechial hemorrhages found on the mucosal and serosal surfaces of the colon and small intestine. The mesenteric lymph nodes were severely edematous.
Laboratory Results: Abundant Shigella flexneri was isolated from the intestine.
Contributor's Diagnosis and Comments: Severe diffuse subacute ulcerative colitis.
Etiology: Shigella flexneri
The colon contains large, focally extensive to confluent areas of mucosal ulceration which are covered by a layer of fibrinopurulent material with hemorrhage. The remaining lamina propria is increased in cellularity due to mononuclear cells with occasional neutrophils. Crypts are dilated and filled with degenerative inflammatory and epithelial cells. Re-epithelialization is occurring along the luminal surface of the mucosa in some areas. The submucosa is markedly edematous with dilated lymphatics, and scattered inflammatory cells. The tunica serosa is also edematous and mildly to moderately infiltrated with mononuclear cells. There are focal hemorrhages on the serosal surface and mesothelial cells are hypertrophic.
The lesions coupled with the culture of abundant organisms lead to a diagnosis of shigellosis.
Shigella is among the most commonly isolated enteric pathogens from laboratory primates. Various serotypes include Shigella flexneri, S. dysenteriae, S. boydii, and S. sonnei. S. flexneri is the most pathogenic and is isolated from the majority of cases. The source of infection is human beings, directly or indirectly; shigellosis is not a disease of wild primates. In colonies, the disease is spread among monkeys via feces. Carriers are common and can constitute the majority of animals in a colony. Stress precipitates the disease. Recovered animals are likely to become carriers. Shigellosis is a zoonosis; usually mild or no disease occurs in adults but it can cause a severe, even fatal disease in children. Human beings may become carriers.
The organism invades and destroys colonic epithelium; M cells
may be the target for the initial infection. Full virulence requires
chromosomal and plasmid genes. After entering the cell, Shigella
replicates in the phagosome, lyses the phagocytic vacuole, and
multiplies within the cytoplasm. The organism elaborates a toxin,
the shiga-toxin, which is cytotoxic for HeLa and Vera cells, and
is comprised of one A subunit and 5 B subunits. The B subunit
binds to cell surface receptors and the A subunit is proteolytically
nicked to an A1 fragment which inhibits protein synthesis in the
target cell. There may also be an enterotoxin responsible for
the secretory diarrhea that can occur with some strains of Shigella.
Clinical signs are variable, and include soft stools with no constitutional
signs to watery diarrhea with mucus, blood or pus. Weakness, prostration,
facial edema, rectal prolapse, and death may occur. Shigellosis
can be epizootic with high morbidity and mortality in susceptible
populations, such as newly caught or imported monkeys, or young
monkeys. Grossly, the colon is distended and red with a thickened
edematous wall. There is a catarrhal, suppurative or fibrinonecrotizing
(diphtheritic) mucosal exudate. There may be mucosal ulceration
and hemorrhage. The mesenteric lymph nodes are enlarged and edematous
and may be hemorrhagic. Differential diagnosis includes salmonellosis,
yersiniosis, and other enteropathogenic infections.
Control is accomplished by hygiene, proper housing and handling, and isolation of affected primates. Treatment with some antibiotics may not eliminate the carrier state, but trimethoprim-sulfamethoxazole has been reported to eliminate carriers.

Conference Note: Several genes involved in invasion of cultured cells have been identified. These genes are designated ipa, for invasion plasmid antigens. At least two of the proteins coded by ipa genes, IpaB and IpaC, are exposed on the bacterial surface and can also be found free in the extracellular fluid. In vitrostudies have proven that these proteins are required for invasion. Though the receptors for Ipa binding have not yet been conclusively identified, current work suggests that Ipa proteins bind to integrins, a proven host cell receptor for other types of invasive bacteria, including Yersinia spp.3 Integrins are located primarily on the basolateral surface of mucosal cells. This supports the hypothesis that the bacteria make their initial entry into the body through the M cells of the Peyer's patches, and subsequently spread to infect enterocytes from below. M cells are naturally phagocytic cells whose primary role is to sample antigens from the lumen of the intestine by phagocytic uptake and presentation to the underlying lymphoid tissue.
After uptake of the bacteria, intracellular actin filaments polymerize at one end of the bacteria, creating comet-like tails and propelling the bacteria through the cytoplasm. The bacteria eventually come into contact with the cell membrane and form protrusions from which they eventually escape, thus allowing intercellular spread.
Shiga toxin is produced by only one Shigella species, S. dysenteriae. This potent exotoxin is structurally similar to cholera toxin. Interestingly, Shiga toxin has the same mechanism and cleaves the host cell 23S rRNA molecule at exactly the same site as ricin, a toxin derived from castor beans, but the two toxins share no significant amino acid sequence similarity.
In addition to enteric lesions, Shigella flexneri has been associated with gingivitis in rhesus, bonnet, and stump-tailed macaques.
Contributor: Department of Comparative Medicine, University of Alabama at Birmingham, 1670 University Blvd, Birmingham, AL 35294-0019.
References:
1. Russell RG, Detolla LJ. Shigellosis. In: Nonhuman Primates II, Jones TC, Mohr U, and Hunt RD, eds., Internat Life Sci Inst, Washington, D.C., pp. 46-53, 1993.
2. Olson LC. Control of Shigella flexneri in Celebes black macaques (Macaca nigra). Lab Anim Sci 36:240-242, 1986.
3. Salyers AA, Whitt DD. Dysentery caused by Shigella species. In: Bacterial Pathogenesis: A Molecular Approach, ASM Press, Washington, D.C., pp. 169-181, 1994.
4. Lowenstine LJ. Pathology of laboratory nonhuman primates (selected diseases). Presented at 44th Annual Pathology of Laboratory Animals seminar, Bethesda, MD, August 1997.
International Veterinary Pathology Slide Bank:
Laser disc frame #9196
Signalment: 8-year-old Burro gelding
History: This burro had numerous, 0.5 to 3.0 cm, raised, subcutaneous swellings in the skin of one hindleg, the perineum, prepuce, scrotum, pectoral and lateral abdominal areas. The lesions were painful and would rupture, releasing thick white fluid. Ruptured lesions had a granulation tissue surface covered by a crust which healed very slowly.
Laboratory Results: Fungal cultures of an unruptured lesion yieldedSporothrix schenkii.
Contributor's Diagnosis and Comments: Dermatitis, pyogranulomatous, chronic, focal, severe, with rare, budding yeasts, skin. (Etiology: Sporothrix schenkii).
Sporothrix schenkii is a dimorphic fungus found in the soil. The geographic distribution is reported as universal but is most common in coastal areas and river valleys of the southern United States and other countries with a similar climate. This case occurred in southeastern Arizona, an arid climate by comparison.
Sporotricosis in horses occurs as cutaneous and cutaneolymphatic forms. The latter is more common and is characterized by cording of the lymphatics and cutaneous nodules which eventually rupture and drain purulent or serosanguineous exudate. The organism gains entrance via inoculation into the skin of an exposed body part (puncture, insect bite, etc.) and the infection progresses as hard nodules developing along lymphatic vessels. The microscopic features are those of diffuse or nodular dermatitis which is suppurative, pyogranulomatous or granulomatous. The organisms are 3 to 6 µm, budding yeasts and are hard to find in the lesions; they may be absent. The organism is easily cultured on Sabouraud's dextrose at 30 C, where it grows as a mold.

In addition to horses, sporotrichosis occurs in mules, cats, dogs, cattle, buffalo, and man. Infection usually follows contamination of skin wounds, but may follow inhalation of the organism, and infected cats can serve as a direct source of transmission to humans. Systemic disease occurs only rarely and primarily affects debilitated or immunosuppressed animals, except in cats. Cats are most prone to develop systemic disease, and immunosuppression appears not to be a prerequisite.
As the contributor notes, the organisms are rarely seen in H&E-stained histologic sections from horses. In cutaneous lesions from cats, however, organisms are typically numerous.
Differential diagnosis of equine sporotrichosis should include glanders [Burkholderia (formerly Pseudomonas) mallei]; epizootic lymphangitis [Histoplasma farciminosum]; melioidosis [Burkholderia pseudomallei]; ulcerative lymphangitis [Corynebacterium pseudotuberculosis]; and strangles [Streptococcus equi].
Contributor: Arizona Veterinary Diagnostic Laboratory, University of Arizona, Tucson, Arizona 85705
References:
1. Blackford J. Superficial and deep mycoses in horses. Vet Clin North Am [Large Anim Pract]. 6:47-58, 1984.
2. Fishburn F, Kelley DC. Sporotrichosis in a horse. J Am Vet Med Assoc. 151:45-46, 1967.
3. Davis HH, Worthington WE. Equine sporotrichosis. J Am Vet Med Assoc 145:692-693, 1964.
4. Yager JA, Scott DW. The Skin and Appendages. In: Pathology of Domestic Animals, 4th edition, Jubb KVF, Kennedy PC, Palmer N, eds, Academic Press, 1993, vol. 1, pp. 668-670.
International Veterinary Pathology Slide Bank:
Laser disc frame #2462, 2505-6, 2797, 5700, 12364, 23304.
Signalment: 23- to 24-day-old male turkey poults
History: The birds came from three separate accessions from various facilities of one commercial producer, from a common source hatchery. They had diverse central nervous system signs including ataxia, torticollis and blindness, and associated increased mortality for periods ranging from 1-3 weeks. Live birds had severe CNS signs.
Gross Pathology: Out of a total of 21 birds that these
tissues were collected from (not all were examined histologically),
10 had grossly evident meningitis and 8 had unilateral or bilateral
panophthalmitis. Visceral lesions were not apparent except for
one bird with pericarditis.
Laboratory Results: Salmonella arizonae was isolated from eye
and brain of multiple birds from each accession, and the intestinal
tract of one bird. (species confirmed by the National Veterinary
Services Laboratory).
Contributor's Diagnosis and Comments: Severe heterophilic leptomeningitis, ependymitis and periependymal encephalitis (ventriculitis), with abundant bacteria. Edema and malacia, cerebellum.

Conference Note: Arizonosis is an acute septicemic disease primarily seen in young turkey poults, and occurs worldwide, with the exception of Great Britain, where it has been eliminated from the turkey industry.3 Over 300 serotypes of the causative agent, Salmonella arizonae (formerly Arizona hinshawii), have been identified. The bacteria can invade the bloodstream and causes mortality of 10 to 50%. Chicks or poults are especially susceptible within the first few days after hatching. S. arizonae is widely distributed in nature in a variety of avian, mammalian, and reptilian species, many of which have been cited as common sources of the organism for poultry flocks. Infected adult birds are frequently asymptomatic carriers. Infection may occur transovarially and by direct penetration of the egg shell.
Lesions in poults are comparable to those induced by the paratyphoid group of salmonellae, including S. typhimurium and S. enteritidis. These include hepatomegaly and mottling of the liver with white foci, retained yolk, caseous exudate in the peritoneal cavity, meningoencephalitis, and cloudy exudate in the anterior chamber of the eye.
Differential diagnosis for CNS disease in poults should include Newcastle disease [a Rubulavirus, in Paramyxoviridae family], aspergillosis, vitamin E deficiency (avian encephalomalacia), and avian encephalomyelitis (AE) [picornavirus]. Other important septicemic diseases in poultry caused by Salmonella species include pullorum disease [S. pullorum] and fowl typhoid [S. gallinarum].
Contributor: Department of Veterinary Pathobiology, University of Missouri, P.O. Box 6023, Columbia MO 65205
References:
1. Whitman CE, Bickford AE. Arizona infection. In: Avian Disease Manual, 3rd edition, American Association of Avian Pathologists, Dubuque, IA, pp. 81-84, 1989.
2. Silva EN, Hipolito O, Grecchi R. Natural and experimental Salmonella arizonae18:z4,z32 (Ar. 7:1, 7,8) infection in broilers. Bacteriological and histopathological survey of eye and brain lesions. Avian Diseases 24:631-636, 1980.
3. Shivaprasad HL, Nagaraja KV, Pomeroy BS, Williams JE. Arizonosis.
In: Diseases of Poultry, 10th edition, Iowa State University Press,
1997; pp. 122-128.
International Veterinary Pathology Slide Bank:
Laser disc frame #20529-32, 20534-35.
Signalment: 6-month-old female homozygous µMT/µMT deficient mouse
History: 4 mice died when anesthetized with methoxyflurane.
Gross Pathology: The lungs were heavy with gray depressed areas surrounded by pale pink lung parenchyma.
Laboratory Results: Lung cultures were sterile for bacteria.
Contributor's Diagnosis and Comments: Lung: interstitial pneumonia;
Pneumocystis carinii; Lung: pneumocystosis.

Conference Note: Conference participants noted the eosinophilic spicular material referenced in diagnosis #2 above. The nature of the material is not clear, but most likely it consists of surfactant-derived lipoproteins. Also discussed was the presence in some sections of multifocal perivascular accumulations of small round cells with plasmacytoid features, resembling plasma cells. Since B cell development in the homozygous µMT-deficient mouse is arrested at the stage of pre-B cell maturation,3 participants wondered if the presence of these apparent plasma cells indicated incomplete penetrance of the mutation.
Pneumocystis carinii (PC) is a pathogenic eukaryotic microorganism that causes severe interstitial pneumonia in immunosuppressed mammals. Recent evidence supports classification of PC as an atypical fungus. It has a worldwide distribution and a broad host range. Its only known habitat is the respiratory system of man and animals. The organism is maintained in nature by aerosol transmission from (primarily) subclinically infected to susceptible animals within a species. Subclinical infections are common in rats, mice, guinea pigs, rabbits, cats, and sheep. Estimates of latent human infection range from 1-10%, but several authors report that 75% of normal humans have serum antibodies to PC by 4 years of age.
Clinical pneumonia occurs spontaneously in dogs, pigs, horses, goats, nonhuman primates, and man, and is almost always associated with deficiencies of cellular and/or humoral immunity. It has been generally assumed that these cases represent activated latent infections. However, Vogel et al5 challenge that view, and have demonstrated that many cases of P. carinii infection in SIV-infected macaques appear to result from horizontal transmission during immunosuppression.
Alveolar macrophages and CD4+ T cells play a key role in the defense of the host against PC. Binding of the organisms to macrophages appears to occur via fibronectin, mannose and (probably) the complement receptors of the macrophage. PC, via -glycan moieties in the cell wall, stimulates a respiratory burst in macrophages as well as arginine uptake and nitric oxide production. The organism appears to posses superoxide dismutase but lacks catalase activity. Therefore, it would be susceptible to H202-dependent killing mechanisms. PC also stimulates production of TNF- , IL-1 and IL-6. Passive administration of antibodies against TNF- and IL-1 blocked recovery from pneumocystosis in mice, whereas antibodies to IL-6 did not.
A specific T cell proliferative response has been demonstrated in animals and healthy humans previously exposed to PC. CD4+ T cells, but not CD8+ T cells, have been found to be essential for resistance to PC pneumonia in Balb/c mice, and in SCID mice reconstituted with splenic cells from immunocompetent mice.
References:
1. Bartlett MS, Current WL, Orazi A, Bauer NL, Neiman RS, Queener SF, Smith JW. Comparison of Corticosteroid- and L3T4+ Antibody-Immunosuppressed Mouse Models of Pneumocystis carinii Pneumonia for Evaluation of Drugs and Leukocytes. Clinical and Diagnostic Laboratory Immunology. 1:511-516; 1994.
2. Hanano R, Reifenberg K, Kaufmann SH. Naturally Acquired Pneumocystis cariniiPneumonia in Gene Disruption Mutant Mice: Roles of Distinct T-Cell Populations in Infection. Infection and Immunity, 64:3201-3209; 1996.
3. Marcotte H, Levesque D, Delanay K, Bourgeault A, de la Durantaye R, Brochu S, Lavoie MC. Pneumocystis carinii Infection in Transgenic B Cell-Deficient Mice. Journal of Infectious Diseases. 173:1034-1037; 1996.
4. McFadden DC, Powles MA, Smith JG, Flattery AM, Kartizal K, Schmatz DM. Use of Anti-CD4+ Hybridoma Cells To Induce Pneumocystis carinii in Mice. Infection and Immunity, 62:4887-4892; 1994.
5. Vogel P, Miller CJ, Lowenstine LL, Lackner AA. Evidence of horizontal transmission of Pneumocystis carinii Simian Immunodeficiency Virus-infected rhesus macaques. Journal of Infectious Diseases 168(4):836-843, Oct 1993.
6. Caillies JC, et al. Pneumocystis carinii: an atypical fungal micro-organism. J Med Vet Mycol 1996 Jul-Aug;34(4):227-39
7. Su TH, Martin WJ. Pathogenesis and host response in Pneumocystis
carinii pneumonia. Annu Rev Med 1994;45:261-72.
International Veterinary Pathology Slide Bank:
Laser disc frame #5290-91, 8448, 8450, 8492-3, 9295, 12374,
19657, 24541-2.
Terrell W. Blanchard
Major, VC, USA
Registry of Veterinary Pathology*
Department of Veterinary Pathology
Armed Forces Institute of Pathology
(202)782-2615; DSN: 662-2615
Internet: blanchard@email.afip.osd.mil
* The American Veterinary Medical Association and the American College of Veterinary Pathologists are co-sponsors of the Registry of Veterinary Pathology. The C.L. Davis Foundation also provides substantial support for the Registry.